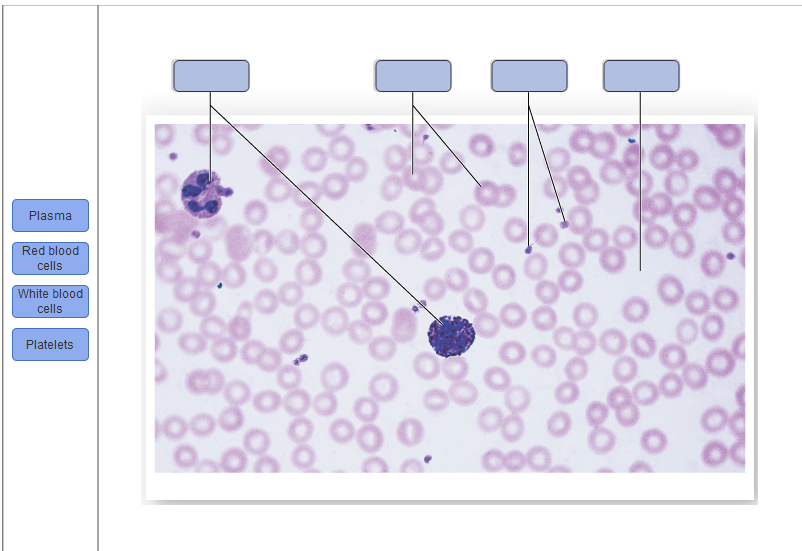

43 red blood cell with labels
Health Bloom 25 8 foods to increase red blood cells count. September 14, 2022. Share. #healty_wealthy. How to lower high blood pressure || 8 quick ways to maintain blood pressure . August 31, 2022. Share. #healty_wealthy. 8 reasons why you might be losing hair ... Labels. Fitness Tips ... 'Stocks Are Looking Increasingly Cheap,' Says J.P. Morgan; Here Are 2 ... Revenues have been steadily increasing over the past few years, a trend that continued when the company delivered its most recent set of results. In 2Q22, the top-line rose by 25.6% year-over-year ...
› newsletter_articleSupplements: A scorecard - Harvard Health Sep 22, 2021 · Even with all these safeguards, problems still occur, prompting the FDA to withdraw many medications and to require strong warning labels on others. The Dietary Supplement Health and Education Act restricts the FDA's ability to regulate products marketed as "dietary supplements," even though most people buy them for health, not nutrition.

Red blood cell with labels
'Stocks Are Looking Increasingly Cheap,' Says J.P. Morgan; Here Are 2 ... Noting several SoC (e.g., HU, Jakafi) come with skin cancer warnings on their respective labels, the potential risk if true, in our view, may not be viewed as a major deterrent for use. Nutrition Tips for Seniors: How to Eat Well Over 65 High blood pressure becomes particularly more common with age, which means seniors are wise to cut back. One of the easiest ways to do it is by reading labels on packaged foods, and substituting spices, herbs and fresh citrus juice (like lemon, lime and orange) for table salt when cooking. 4. Get enough protein. › blood-transfusionBlood transfusion | healthdirect Donated blood can be split into different parts. You will be given the part or parts of the blood your body needs. This could be: red blood cells — to carry oxygen to tissues and organs; platelets — to help stop bleeding; plasma — for blood clotting factors (which help stop bleeding), along with other proteins and antibodies
Red blood cell with labels. 'Stocks Are Looking Increasingly Cheap,' Says J.P. Morgan; Here Are 2 ... The company's pipeline boasts two separate research paths, one focused on hematology and blood disorders and one for the treatment of inflammatory and immunomodulatory diseases. › Life-Extension-Protein-300mgAmazon.com: Life Extension Iron Protein Plus – Highly ... Life Extension Iron Protein Plus – Highly Absorbable Form of Irons Supplement Pills for Red Blood Cell & Protein Production – Once Daily - Gluten-Free, Non-GMO, Vegetarian – 100 Capsules Page 1 of 1 Start over Page 1 of 1 Cereals Fortified with Iron: Best Options to Go - New Health Advisor Eat any of these iron-rich foods with the vitamin C foods below for extra absorption. Red meat Poultry Beans Pork Seafood Peas Dried fruits Dark leafy greens Breads, pastas, and cereals that have been iron-fortified Please note that the iron in meat is absorbed in larger amount than from other sources. RBC Blood Test: Normal Ranges and Diagnostic Uses - Verywell Health The red blood cell (RBC) count is a test that measures the number of oxygen-carrying blood cells in your blood. An abnormal RBC test result is often the first sign of an illness. At other times, the test can point the doctor in the direction of a diagnosis if there are symptoms like unexplained fatigue or shortness of breath.
Sickle Cell Disease - Genome.gov Definition. 00:00. …. Sickle cell disease is a hereditary disease seen most often among people of African ancestry. Caused by mutations in one of the genes that encode the hemoglobin protein, the disease is inherited as an autosomal recessive trait. The mutation causes the red blood cells to take on an unusual sickle shape. hospital.blood.co.uk › red-cell-immunohaematologyRed Cell Immunohaematology - Hospitals and Science - NHSBT Follow-up red cell serology for antenatal patients with red cell antibodies, including quantification and titration of antibodies. Investigations of blood grouping problems. Genotyping for selected cases and haemoglobinopathy patients. Investigation of red cell antibodies, including cross-matching in cases of transfusion problems. PKH26 Red Fluorescent Cell Membrane Labeling Sigma-Aldrich It has been characterized in a number of model systems and has been found to be useful for in vitro cell labeling, in vitro proliferation studies and long term, in vivo cell tracking. The half-life for elution of PKH26 from labeled rabbit red blood cells is greater than 100 days. This enhanced stability is favorable for long term in vivo studies. Stock Market | FinancialContent Business Page ABC008 has been designed to treat diseases mediated by highly cytotoxic T cells, including the autoimmune muscle disease inclusion body myositis (IBM), T cell large granular lymphocytic leukemia (T-LGLL), and mature T cell malignancies. The US Food and Drug Administration (FDA) has granted Orphan Drug Designation to ABC008 for the treatment of IBM.
Kidney Structures and Functions Explained (with Picture and Video) Regulates red blood cells: The kidneys produce erythropoietin, a hormone that stimulates your bone marrow to produce more red blood cells when the bodydoes not get enough oxygen. Regulates acid levels: Acids are products of metabolism. The kidneys help maintain proper acid-base balance to keep the body healthy. Stock Market | Daily Herald ABC008 has been designed to treat diseases mediated by highly cytotoxic T cells, including the autoimmune muscle disease inclusion body myositis (IBM), T cell large granular lymphocytic leukemia... 5 White Blood Cells Types and Their Functions - New Health Advisor Neutrophils are the first cells to reach an area where a breach in the body has been made. They kill germs by means of a process known as phagocytosis or "cell-eating". Besides eating bacteria one-by-one, they also release a burst of super oxides that have the ability to kill many bacteria at the same time. 2. Lymphocytes › blood-typesBlood types | healthdirect These names indicate whether the blood’s red cells carry the A antigen, the B antigen, both A and B antigens, or neither antigen. Each of the 4 blood groups can be classified as either Rhesus positive or Rhesus negative. The Rhesus system looks at different antigens on the surface of the red blood cells.
PDF Blood Components Database for the Recipient Epidemiology and Donor ... o Blood Systems Research Institute in San Francisco To meet the objectives of REDS-III data were collected to produce three sets of core files. The donor/donation files . contain information on attempted and successful donations of whole blood and blood products, as well as deferrals and the reasons for them. The . component files contain
Abcuro Initiates Phase 1/2 Trial Evaluating ABC008 in Patients with T ... T-LGLL is an autoimmune disorder characterized by clonally expanded CD3+ CD8+ cytotoxic T lymphocytes which attack neutrophils and red blood cell precursors, leading to neutropenia and anemia.
› projects › gap3.7.2 Collection, Processing, and Shipping of Blood Samples to correspond with each participant’s blood collection tube rack. It may be helpful to have the red cryovials in a separate rack, because the red serum collection tubes are generally centrifuged at a different time from the other tubes. 5.3 Priority of tubes Approximately 65.5 mL of blood will be drawn from each participant
Recombinant Anti-fetal hemoglobin antibody [EPR9708(B)] (ab137096) All lanes : Anti-fetal hemoglobin antibody [EPR9708(B)] (ab137096) at 1/2000 dilution (Unpurified) Lane 1 : Human red blood cell Lane 2 : K562 (human lymphoblast from chronic myelogenous leukemia) whole cell lysate Lysates/proteins at 20 µg per lane. Secondary All lanes : Goat Anti-Rabbit IgG H&L (HRP) at 1/1000 dilution Predicted band size: 16 kDa Blocking and Diluting Buffer:5% NFDM/TBST
Hematology Practicals | Paramedics World INTRODUCTION TO HEMOGLOBIN Hemoglobin (Hb or Hgb) is a red color pigment present in red blood cells (RBCs) comprises Fe2+ and Globin protein. It is Hemoglobin in RBCs that carries the oxygen from the lungs to the tissues and CO2 from body tissues to the lungs for excretion. Hemoglobin (Hb ... Continue Reading.....
The rise of computational medicine - Harvard Health In this disease, misshapen red blood cells clog up small blood vessels, leading children and young adults to have recurrent bouts of excruciating pain and even strokes and heart attacks. Pauling bet that the children had inherited a defect in a specific protein, globin, that caused the protein, and then the red blood cell, to become misshapen.
pubchem.ncbi.nlm.nih.gov › compound › pyridoxinePyridoxine | C8H11NO3 - PubChem Pyridoxine | C8H11NO3 | CID 1054 - structure, chemical names, physical and chemical properties, classification, patents, literature, biological activities, safety ...
Circulatory System Diagram | New Health Advisor There are different types of circulatory system diagrams; some have labels while others don't. The color blue stands for deoxygenated blood while red stands for blood which is oxygenated. Below you'll see diagram specified to the heart, as well as circulatory system diagram of the whole body: How Does the Human Circulatory System Work? 1. Heart
Iodine - Health Professional Fact Sheet - National Institutes of Health According to its label, iodized salt in the United States contains 45 mcg iodine/g salt (between 1/8 and 1/4 teaspoon); measured salt samples have an average of 47.5-50.7 mcg iodine/g salt [8,18]. However, most salt intake in the United States comes from processed foods, and food manufacturers almost always use non-iodized salt in these foods.
› blood-transfusionBlood transfusion | healthdirect Donated blood can be split into different parts. You will be given the part or parts of the blood your body needs. This could be: red blood cells — to carry oxygen to tissues and organs; platelets — to help stop bleeding; plasma — for blood clotting factors (which help stop bleeding), along with other proteins and antibodies
Nutrition Tips for Seniors: How to Eat Well Over 65 High blood pressure becomes particularly more common with age, which means seniors are wise to cut back. One of the easiest ways to do it is by reading labels on packaged foods, and substituting spices, herbs and fresh citrus juice (like lemon, lime and orange) for table salt when cooking. 4. Get enough protein.
'Stocks Are Looking Increasingly Cheap,' Says J.P. Morgan; Here Are 2 ... Noting several SoC (e.g., HU, Jakafi) come with skin cancer warnings on their respective labels, the potential risk if true, in our view, may not be viewed as a major deterrent for use.

Post a Comment for "43 red blood cell with labels"